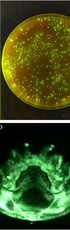
Pathogenicity and transmission of Morganella morganii in honey bees

01/07/2026
research article
Evaluating modes of influenza transmission (EMIT-2): Insights from lack of transmission in a controlled transmission trial with naturally infected donors
Human-to-human influenza virus transmission under controlled conditions could provide insights leading to better control of epidemics and pandemics. However, a previous study using laboratory adapted viruses produced minimal transmission.
Image credit: NIAID

Connect with Us